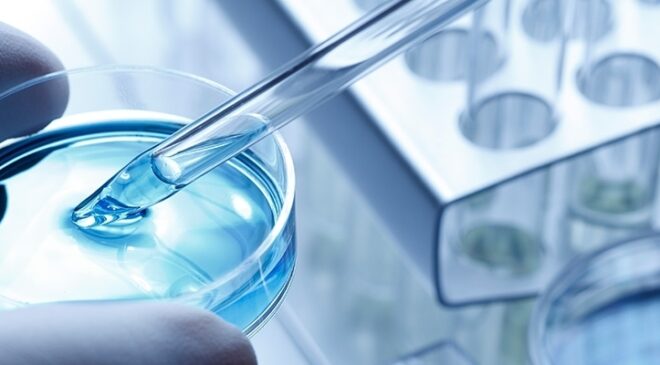
Shionogi, nuove evidenze real-world supportano cefiderocol nelle infezioni da patogeni multiresistenti

L’AIFA ha ammesso alla rimborsabilità erdafitinib, la prima target therapy per il trattamento del carcinoma uroteliale non resecabile o metastatico in pazienti adulti che presentino alterazioni genetiche del fattore di crescita dei fibroblasti FGFR3, e che abbiano ricevuto in precedenza almeno una linea di terapia, tra cui un inibitore del recettore della morte programmata 1 (PD-1) o del suo ligando…
LeggiAIFA: dupilumab ammesso alla rimborsabilità per due nuove indicazioni
Il Consiglio di Amministrazione dell’AIFA, nella seduta del 19 novembre, ha ammesso alla rimborsabilità due estensioni di indicazione terapeutica per l’anticorpo monoclonale dupilumab e un nuovo generico di un farmaco antivirale. Dupixent (dupilumab) sarà rimborsato per le nuove indicazioni nell’ambito del trattamento della broncopneumopatia cronica ostruttiva (BPCO) e dell’esofagite eosinofila, malattia infiammatoria cronica dell’esofago. Il secondo farmaco ammesso alla rimborsabilità…
LeggiIndia, stretta sulla responsabilità nella filiera del farmaco. Licenze distinte tra aziende produttrici e commerciali
L’ente regolatorio indiano prepara una stretta sull’intera filiera che porta alla commercializzazione dei farmaci. Il Central Drugs Standard Control Organization (CDSCO) sta valutando l’introduzione di una licenza ad hoc per le aziende che svolgono attività di marketing e vendita, distinta da quelle già previste per produttori, grossisti e distributori. La mossa nasce dalle criticità emerse negli ultimi anni sulla qualità…
LeggiHealthcare tedesco in Italia: ogni euro investito ne genera tre e l’innovazione traina il sistema
Le imprese farmaceutiche e medtech a capitale tedesco confermano il loro ruolo strategico per la crescita e la sostenibilità del sistema healthcare italiano. Nel 2023 il valore della produzione ha raggiunto 5,4 miliardi di euro – circa l’8% del totale nazionale – con oltre 9.000 occupati diretti. Secondo lo studio “L’impatto delle imprese healthcare a capitale tedesco in Italia”, realizzato…
LeggiAlkermes rilancia per acquisire Avadel e supera Lundbeck: offerta da 2,37 miliardi di dollari
Dopo il blitz di Lundbeck nella trattativa, Alkermes ha presentato una nuova offerta per acquisire Avadel Pharmaceuticals: 22,50 dollari per azione, di cui 21 in contanti e 1,50 dollari come valore contingente (CVR), legato all’eventuale approvazione da parte della FDA di Lumryz nel trattamento dell’ipersonnia idiopatica entro la fine del 2028. Con questa offerta, la valutazione complessiva della biotech USA…
LeggiTeva lancia Teva Rise, piattaforma globale di open innovation
Teva Pharmaceutical ha annunciato il lancio di Teva Rise, una piattaforma di open innovation rivolta a startup e aziende biotech di tutto il mondo. L’obiettivo è affrontare le sfide più rilevanti del settore farmaceutico in R&S, produzione, supply chain e area commerciale, accelerando lo sviluppo di soluzioni innovative grazie anche all’uso dell’intelligenza artificiale. Secondo i dirigenti della pharma israeliana, la…
LeggiAudioNova Italia acquisisce Mondial Udito e rafforza la presenza nel Nord Italia
AudioNova Italia, parte del business retail del Gruppo Sonova, ha completato l’acquisizione di Mondial Udito, storica realtà lombarda fondata nel 1995 e presente nelle province di Como, Lecco, Sondrio e Cantù. L’operazione integra quattro nuovi punti vendita nella rete AudioNova, consolidandone la presenza nel Nord Italia. “Continua il nostro piano di espansione, che prevede una crescita attraverso acquisizioni e aperture…
LeggiDiagnostica in vitro: il mercato italiano verso i 5 miliardi di dollari entro il 2033
Il mercato italiano della diagnostica in vitro (IVD) continua a mostrare una crescita robusta. Secondo il report “Italy In-Vitro Diagnostics (IVD) Market Size and Share Analysis – Growth Trends and Forecast Report 2025-2033,” redatto dalla piattaforma di informazioni di mercato ResearchAndMarkets.com, il settore potrebbe arrivare a valere 5,03 miliardi di dollari entro il 2033, con un tasso di crescita annuale…
LeggiCelltrion nuovo player nel mercato dell’obesità?
Celltrion accelera sul fronte dell’obesità, preparandosi a entrare in uno dei segmenti più dinamici e competitivi della farmaceutica mondiale. La biotech sudcoreana sta sviluppando una formulazione orale pensata per competere direttamente con i blockbuster iniettabili come Wegovy di Novo Nordisk e Mounjaro di Eli Lilly, aprendo così un nuovo fronte nella corsa alle terapie anti-obesità. La notizia, riportata dai media…
LeggiMinistero della Salute. Giovanni Migliore sarà il nuovo Dg della Comunicazione
Sarà Giovanni Migliore il nuovo direttore generale della Comunicazione del Ministero della Salute. Migliore, 64 anni, è docente di “direzione strategica delle aziende sanitarie” nella Scuola di Medicina dell’Università degli Studi di Bari “Aldo Moro”, ha una decennale esperienza di “management” alla guida di grandi aziende sanitarie pubbliche ed una particolare competenza nelle aree dei sistemi informativi, del disegno e…
Leggi“Aderire per Vincere”: Servier e Associazioni Pazienti insieme per rafforzare l’aderenza terapeutica nelle patologie cardiovascolari
Entra nel vivo la seconda edizione del contest “Aderire per Vincere”, l’iniziativa promossa dal Gruppo Servier in Italia in collaborazione con la Fondazione Italiana per il Cuore (FIPC), patrocinata da CONACUORE – Coordinamento Nazionale delle Associazioni del Cuore, Società Italiana di Cardiologia (SIC), Società Italiana di Medicina Interna (SIMI), Associazioni Regionali Cardiologi Ambulatoriali (ARCA), Società Italiana dell’Ipertensione Arteriosa (SIIA) e…
LeggiInsmed: CE approva brensocatib, trattamento “first in class” per la NCFB
La Commissione Europea ha dato il via libera a brensocatib (Brinsupri) compresse da 25 mg per il trattamento delle bronchiectasie non correlate alla fibrosi cistica (NCFB) in pazienti dai 12 anni in su con almeno due esacerbazioni nell’ultimo anno. Si tratta del primo e unico farmaco approvato in Europa per questa malattia, sottoposto a valutazione accelerata dall’EMA per il suo…
LeggiBiogen: il CHMP dell’EMA raccomanda il regime ad alto dosaggio di nusinersen nella SMA
Il CHMP dell’EMA ha raccomandato l’approvazione del regime ad alto dosaggio di nusinersen per il trattamento dell’atrofia muscolare spinale (SMA) di tipo 5q, la forma più comune della malattia, che rappresenta circa il 95% dei casi. La parola passa ora alla Commissione Europea, la cui decisione è attesa a gennaio 2026. Il parere positivo del CHMP si basa sui dati…
LeggiMalattie rare: Fondazione Telethon verso il traguardo della prima terapia genica approvata in Europa
La Fondazione Telethon si avvicina a un traguardo storico: portare in Europa la prima terapia genica destinata alla sindrome di Wiskott-Aldrich (WAS). Il CHMP dell’EMA ha infatti raccomandato l’approvazione di Waskyra (etuvetidigene autotemcel) – messa a punto dai ricercatori della Fondazione italiana – per pazienti di età pari o superiore a sei mesi affetti da questa rara malattia immuno-ematologica. “Questo…
LeggiJ&J acquisisce Halda per 3 miliardi di dollari e rafforza la pipeline oncologica
Johnson & Johnson accelera sull’oncologia di nuova generazione. Il gruppo americano ha annunciato l’acquisizione della biotech statunitense Halda Therapeutics per circa 3 miliardi di dollari in contanti, un’operazione che segna un ulteriore rafforzamento del portafoglio R&D nelle terapie mirate per i tumori solidi. Una piattaforma innovativa: le chimere RIPTAC Halda è considerata una delle realtà più promettenti nell’oncologia di prossima…
LeggiGSK e Fleming Initiative, sei grandi sfide alla resistenza antimicrobica
GSK e la Fleming Initiative hanno annunciato sei nuovi importanti programmi di ricerca, denominati “Grand Challenges“, che sfruttano alcune delle migliori competenze scientifiche e le tecnologie più recenti, tra cui l’Intelligenza Artificiale avanzata, per mettere a punto soluzioni in grado di rallentare la crescente resistenza antimicrobica (AMR) nel mondo. Sei “Grandi Sfide” che vengono illustrate durante la Settimana mondiale di…
Leggi